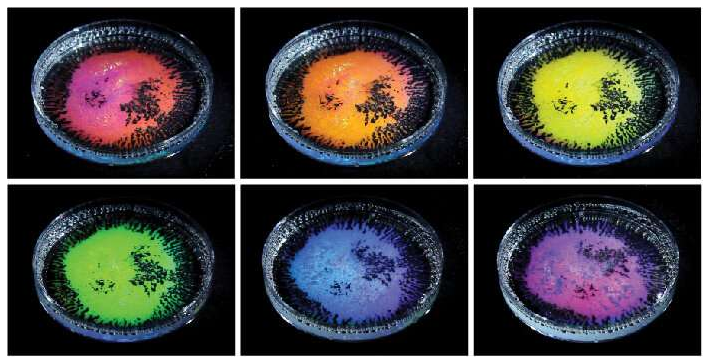
含有透明液滴乳液的培養皿，所述透明液滴乳液由不同密度的油和從不同角度拍攝的水基表面活性劑的混合物制成。當用白光照射時，油滴根據觀察方向反射不同的顏色。新的研究解釋了這種“結構顏色”是如何根據液滴的大小和曲率以及液滴的全內反射形成的。圖片來源：賓夕法尼亞州扎爾扎爾實驗室

清晰的水滴產生彩虹色
含有透明液滴乳液的培養皿,所述透明液滴乳液由不同密度的油和從不同角度拍攝的水基表面活性劑的混合物制成。當用白光照射時,油滴根據觀察方向反射不同的顏色。新的研究解釋了這種“結構顏色”是如何根據液滴的大小和曲率以及液滴的全內反射形成的。圖片來源:賓夕法尼亞州扎爾扎爾實驗室
麻省理工學院和賓夕法尼亞州立大學的工程師們發現,在適當的條件下,透明表面上的普通清水滴可以產生鮮艷的色彩,而無需添加油墨或染料。
在今天發表在“ 自然”雜志上的一篇論文中,該團隊報告稱,如果每個微小的液滴尺寸完全相同,那么用細小的透明液滴霧覆蓋并用單個燈點亮的表面應該會產生明亮的顏色。這種虹彩效果是由于“ 結構顏色 ”,由于光與其幾何結構相互作用的方式,物體通過該“ 結構顏色 ”產生顏色。這種效果可以解釋某些虹彩現象,例如塑料盤或水瓶內的彩色冷凝。
研究人員開發了一種模型,可根據特定的結構和光學條件預測液滴產生的顏色。該模型可用作設計指南,例如,基于液滴的石蕊試驗,或化妝產品中的變色粉末和油墨。
“消費品中用于制造鮮艷色彩的合成染料可能不如它們應該的那樣健康,”麻省理工學院機械工程助理教授Mathias Kolle說。“由于這些染料中的一些受到更強烈的監管,公司們會問,我們能否使用結構色來代替潛在的不健康染料?感謝Amy Goodling和Lauren Zarzar在賓夕法尼亞州立大學的仔細觀察以及Sara的造型,這帶來了這種效果和對光的物理解釋,可能有一個答案。“
麻省理工學院的Sara Nagelberg,以及主要作者Goodling,Zarzar和賓夕法尼亞州立大學的其他人,都是Kolle在論文中的合著者。
跟著彩虹
去年,Zarzar和Goodling正在研究由不同密度的油混合物制成的透明液滴乳液。他們觀察到液滴在透明的培養皿中的相互作用,當他們注意到液滴出現了驚人的藍色。他們拍了一張照片然后把它送到了Kolle,問了一個問題:為什么這里有顏色?

結構顏色來自清澈的水滴。凝聚在透明塑料片上的微米級水滴根據其尺寸反射不同的亮色。圖片來源:賓夕法尼亞州扎爾扎爾實驗室
最初,Kolle認為顏色可能是由于引起彩虹的影響,其中陽光被雨滴重定向,并且各個顏色被分成不同的方向。在物理學中,米氏散射理論用于描述諸如雨滴之類的球體散射電磁波平面的方式,例如入射的太陽光。但Zarzar和Goodling觀察到的水滴不是球體,而是半球形或圓頂形的平面。“最初我們遵循了這種引起彩虹效應的效果,”Nagelberg說道,他負責模擬這項研究以解釋其效果。“但事實證明這是完全不同的事情。”
她注意到球隊的半球形水滴打破了對稱性,這意味著它們不是完美的球體 - 一個看似明顯的事實,但仍然是一個重要的事實,因為它意味著光在半球與球體之間應該表現不同。具體地,半球的凹面允許在完美球體中不可能的光學效應:全內反射或TIR。
全內反射是這樣一種現象,其中光以高角度照射高折射率介質(例如水)與低折射率介質(例如空氣)之間的界面,使得100%的光被反射。這是一種允許光纖以低損耗攜帶數公里光的效果。當光進入單個液滴時,它會被TIR沿其凹面界面反射。
事實上,一旦光線進入液滴,Nagelberg發現它可以采取不同的路徑,在以另一個角度退出之前反彈兩次,三次或更多次。光線在退出時加起來的方式決定了液滴是否會產生顏色。

企鵝的圖像從水滴中的油反射; 示出了反射藍色和綠色光的每種類型的液滴的圖像。企鵝是通過使用光響應性表面活性劑和光致圖案化的液滴形狀制成的。圖片來源:賓夕法尼亞州扎爾扎爾實驗室
例如,包含所有可見光波長的兩束白光以相同的角度進入并以相同的角度射出,可以在液滴內采用完全不同的路徑。如果一條光線反射三次,它的路徑比反射兩次的光線長,因此在退出液滴之前它稍微滯后。如果這種相位滯后導致兩條射線的波同相(意味著波的波谷和波峰對齊),則可以看到對應于該波長的顏色。這種干擾效應最終會產生明顯液滴的顏色,在小而不是大的液滴中會更強。
“當有干擾時,就像孩子們在游泳池里掀起波浪一樣,”科勒說。“如果他們做任何他們想做的事情,就沒有任何建設性的努力加起來,只是池中有很多混亂,或隨機的波浪模式。但如果他們全都推擠,你會得到一個大浪。這里也是一樣的:如果你出現波浪,你會得到更多的色彩強度。“
地毯的顏色
液滴產生的顏色還取決于結構條件,例如液滴的大小和曲率,以及液滴的折射率。Nagelberg將所有這些參數納入數學模型,以預測在某些結構和光學條件下液滴會產生的顏色。然后,Zarzar和Goodling測試了該模型對實驗室中產生的實際液滴的預測。
首先,該團隊優化了他們的初始實驗,創建了液滴乳液,使用微流體裝置可以精確控制其尺寸。正如Kolle描述的那樣,他們在一個透明的培養皿中制作了一個完全相同尺寸的液滴“地毯”,用一根固定的白光照亮它們。然后他們用一個在盤子周圍盤旋的相機記錄了液滴,并觀察到液滴呈現出絢麗的色彩,隨著相機在周圍盤旋而移動。這證明了看到光進入液滴的角度如何影響液滴的顏色。
該團隊還在單個膠片上產生各種尺寸的液滴,并觀察到從單個觀察方向,隨著液滴尺寸增加,顏色會變紅,然后循環回藍色并再次循環。根據模型,這是有道理的,因為較大的液滴會使光線有更大的反彈空間,從而形成更長的路徑和更大的相位滯后。為了證明液滴顏色的曲率的重要性,該團隊在透明薄膜上產生水凝結,該薄膜用疏水(防水)溶液處理,液滴形成大象的形狀。疏水部分產生更多的凹形液滴,而薄膜的其余部分產生更淺的液滴。與淺液滴相比,光可以更容易在凹滴中反彈。結果是一個非常多彩的大象圖案黑色背景。
除液滴外,研究人員還從各種透明的聚合物基材料中打印出微小的實心瓶蓋和圓頂,并在這些固體顆粒中觀察到類似的彩色效果,這可以通過團隊的模型預測。Kolle希望該模型可用于設計一系列變色應用的液滴和顆粒。
“你可以使用復雜的參數空間,”Kolle說。“你可以定制液滴的大小,形態和觀察條件,以創造你想要的顏色。”
更多信息: 在微觀凹面界面處的全內反射和干涉著色,
Nature(2019)。DOI:10.1038 / s41586-019-0946-4,
https ://www.nature.com/articles/s41586-019-0946-4
期刊參考: 自然
提供: 麻省理工學院
(轉載僅供參考學習及傳遞有用信息,版權歸原作者所有,如侵犯權益,請聯系刪除)

